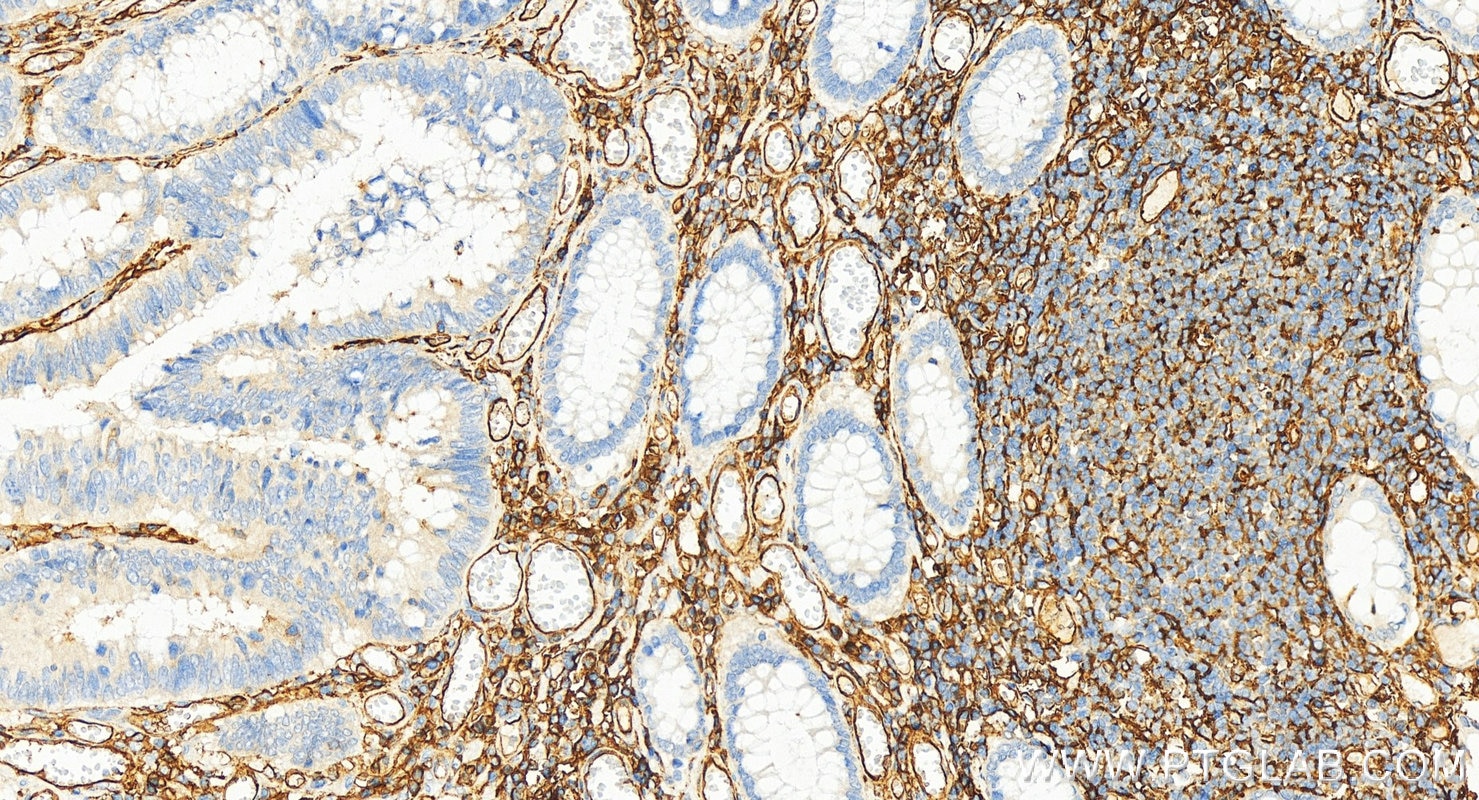

Tested Applications
| Positive WB detected in | HUVEC cells, Raji cells, HeLa cells, L02 cells |
| Positive IP detected in | Raji cells |
| Positive IHC detected in | human colon cancer tissue, human heart tissue Note: suggested antigen retrieval with TE buffer pH 9.0; (*) Alternatively, antigen retrieval may be performed with citrate buffer pH 6.0 |
Recommended dilution
| Application | Dilution |
|---|---|
| Western Blot (WB) | WB : 1:500-1:2000 |
| Immunoprecipitation (IP) | IP : 0.5-4.0 ug for 1.0-3.0 mg of total protein lysate |
| Immunohistochemistry (IHC) | IHC : 1:1000-1:4000 |
| It is recommended that this reagent should be titrated in each testing system to obtain optimal results. | |
| Sample-dependent, Check data in validation data gallery. | |
Published Applications
| WB | See 6 publications below |
| IHC | See 2 publications below |
| IF | See 2 publications below |
Product Information
15364-1-AP targets ICAM-1/CD54 in WB, IHC, IF, IP, ELISA applications and shows reactivity with human samples.
| Tested Reactivity | human |
| Cited Reactivity | human, mouse |
| Host / Isotype | Rabbit / IgG |
| Class | Polyclonal |
| Type | Antibody |
| Immunogen |
CatNo: Ag8309 Product name: Recombinant human ICAM-1 protein Source: e coli.-derived, PET28a Tag: 6*His Domain: 181-532 aa of BC015969 Sequence: GANFSCRTELDLRPQGLELFENTSAPYQLQTFVLPATPPQLVSPRVLEVDTQGTVVCSLDGLFPVSEAQVHLALGDQRLNPTVTYGNDSFSAKASVSVTAEDEGTQRLTCAVILGNQSQETLQTVTIYSFPAPNVILTKPEVSEGTEVTVKCEAHPRAKVTLNGVPAQPLGPRAQLLLKATPEDNGRSFSCSATLEVAGQLIHKNQTRELRVLYGPRLDERDCPGNWTWPENSQQTPMCQAWGNPLPELKCLKDGTFPLPIGESVTVTRDLEGTYLCRARSTQGEVTRKVTVNVLSPRYEIVIITVVAAAVIMGTAGLSTYLYNRQRKIKKYRLQQAQKGTPMKPNTQATPP Predict reactive species |
| Full Name | intercellular adhesion molecule 1 |
| Calculated Molecular Weight | 90 kDa |
| Observed Molecular Weight | 85-95 kDa |
| GenBank Accession Number | BC015969 |
| Gene Symbol | ICAM-1 |
| Gene ID (NCBI) | 3383 |
| ENSEMBL Gene ID | ENSG00000090339 |
| RRID | AB_2122050 |
| Conjugate | Unconjugated |
| Form | Liquid |
| Purification Method | Antigen affinity purification |
| UNIPROT ID | P05362 |
| Storage Buffer | PBS with 0.02% sodium azide and 50% glycerol, pH 7.3. |
| Storage Conditions | Store at -20°C. Stable for one year after shipment. Aliquoting is unnecessary for -20oC storage. 20ul sizes contain 0.1% BSA. |
Background Information
Where is ICAM-1 expressed?
Intercellular Adhesion Molecule 1 (ICAM-1), also known as Cluster of Differentiation 54 (CD54) is a transmembrane glycoprotein constitutively expressed at low levels in endothelial cells, pericytes and on some lymphocytes and monocytes1. It is located at the cytoplasmic membrane, with a large extracellular region of mainly hydrophobic amino acids joined to a small transmembrane region and a cytoplasmic tail. It has a molecular weight of 75 to 115 kDa depending on the level of glycosylation.
What is the function of ICAM-1?
ICAM-1 is important in both innate and adaptive immune responses as an adhesion molecule. Although it is constitutively expressed, in the presence of pro-inflammatory cytokines such as TNFα the endothelial cells are activated and upregulate expression of ICAM-12. In blood vessels lined with endothelial cells, leukocytes that are rolling over the surface are able to bind to ICAM-1 and transmigrate through the endothelial barrier and into the tissue. The initial binding of the leukocytes to ICAM-1 causes a Ca2+ release that initiates endothelial cell contraction and weakening of the intercellular tight junctions3, 4. This protein can be used as an indicator of endothelial activation and of vascular inflammation.
What is the role of ICAM-1 in disease?
Beyond the role in the immune response, ICAM-1 has also been identified as the target of attachment for the human rhinovirus, the cause of the common cold. Binding of the virus to ICAM-1 causes the viral capsid to uncoat and leads to release of the genetic material5.
Hubbard, A. K. & Rothlein, R. Intercellular adhesion molecule-1 (ICAM-1) expression and cell signaling cascades. Free Radic. Biol. Med. 28, 1379-86 (2000).
Long, E. O. ICAM-1: getting a grip on leukocyte adhesion. J. Immunol. 186, 5021-3 (2011).
Lawson, C. & Wolf, S. ICAM-1 signaling in endothelial cells. (2009).
Lyck, R. & Enzmann, G. The physiological roles of ICAM-1 and ICAM-2 in neutrophil migration into tissues. Curr. Opin. Hematol. 22, 53-59 (2015).
Xing, L., Casasnovas, J. M. & Cheng, R. H. Structural analysis of human rhinovirus complexed with ICAM-1 reveals the dynamics of receptor-mediated virus uncoating. J. Virol. 77, 6101-7 (2003).
Protocols
| Product Specific Protocols | |
|---|---|
| IHC protocol for ICAM-1/CD54 antibody 15364-1-AP | Download protocol |
| IP protocol for ICAM-1/CD54 antibody 15364-1-AP | Download protocol |
| WB protocol for ICAM-1/CD54 antibody 15364-1-AP | Download protocol |
| Standard Protocols | |
|---|---|
| Click here to view our Standard Protocols |
Publications
| Species | Application | Title |
|---|---|---|
ACS Nano Antigen Self-Presented Personalized Nanovaccines Boost the Immunotherapy of Highly Invasive and Metastatic Tumors | ||
Acta Pharm Sin B Pulmonary endothelium-targeted nanoassembly of indomethacin and superoxide dismutase relieves lung inflammation | ||
Curr Pharm Biotechnol Naringin inhibits TNF-α induced oxidative stress and inflammatory response in HUVECs via Nox4/NF-κ B and PI3K/Akt pathways. | ||
J Mol Histol Prognostic prediction and diagnostic role of intercellular adhesion molecule-1 (ICAM1) expression in clear cell renal cell carcinoma. | ||
Int Ophthalmol Sodium butyrate inhibits activation of ROS/NF-κB/NLRP3 signaling pathway and angiogenesis in human retinal microvascular endothelial cells | ||
Redox Biol Sulfhydrated albumin transmits H2S signaling and ameliorates DOX-induced multiorgan injuries |